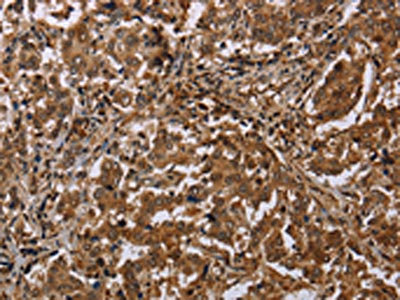

MFF Antibody
-
中文名稱:MFF兔多克隆抗體
-
貨號:CSB-PA064639
-
規格:¥1100
-
圖片:
-
The image on the left is immunohistochemistry of paraffin-embedded Human esophagus cancer tissue using CSB-PA064639(MFF Antibody) at dilution 1/20, on the right is treated with synthetic peptide. (Original magnification: ×200)
-
The image on the left is immunohistochemistry of paraffin-embedded Human liver cancer tissue using CSB-PA064639(MFF Antibody) at dilution 1/20, on the right is treated with synthetic peptide. (Original magnification: ×200)
-
Gel: 8%SDS-PAGE, Lysate: 40 μg, Lane: Mouse brain tissue, Primary antibody: CSB-PA064639(MFF Antibody) at dilution 1/200, Secondary antibody: Goat anti rabbit IgG at 1/8000 dilution, Exposure time: 10 seconds
-
-
其他:
產品詳情
-
Uniprot No.:
-
基因名:MFF
-
別名:C2orf33 antibody; Chromosome 2 open reading frame 33 antibody; DKFZp666J168 antibody; GL004 antibody; Mff antibody; MFF_HUMAN antibody; MGC110913 antibody; Mitochondrial fission factor antibody; OTTHUMP00000164235 antibody
-
宿主:Rabbit
-
反應種屬:Human,Mouse,Rat
-
免疫原:Synthetic peptide of Human MFF
-
免疫原種屬:Homo sapiens (Human)
-
標記方式:Non-conjugated
-
抗體亞型:IgG
-
純化方式:Antigen affinity purification
-
濃度:It differs from different batches. Please contact us to confirm it.
-
保存緩沖液:-20°C, pH7.4 PBS, 0.05% NaN3, 40% Glycerol
-
產品提供形式:Liquid
-
應用范圍:ELISA,WB,IHC
-
推薦稀釋比:
Application Recommended Dilution ELISA 1:2000-1:5000 WB 1:500-1:2000 IHC 1:25-1:100 -
Protocols:
-
儲存條件:Upon receipt, store at -20°C or -80°C. Avoid repeated freeze.
-
貨期:Basically, we can dispatch the products out in 1-3 working days after receiving your orders. Delivery time maybe differs from different purchasing way or location, please kindly consult your local distributors for specific delivery time.
-
用途:For Research Use Only. Not for use in diagnostic or therapeutic procedures.
相關產品
靶點詳情
-
功能:Plays a role in mitochondrial and peroxisomal fission. Promotes the recruitment and association of the fission mediator dynamin-related protein 1 (DNM1L) to the mitochondrial surface. May be involved in regulation of synaptic vesicle membrane dynamics by recruitment of DNM1L to clathrin-containing vesicles.
-
基因功能參考文獻:
- Data show that increasing dynamin-related protein 1 (Drp1) SUMOylation by knocking down SUMO1-sentrin-SMT3 specific protease 3 (SENP3) reduces both Drp1 binding to mitochondrial fission factor protein (Mff) and stress-induced cytochrome c release. PMID: 28262828
- expressions of TIA-1 and MFF were augmented in the cancerous liver tissues compared to the corresponding non-tumor tissues at mRNA and protein level, while the levels of miR-200a-3p and miR-27a/b were relatively lower in the cancerous liver tissues PMID: 29496454
- We suggest that, even if laboratory findings are not indicative of mitochondrial or peroxisomal dysfunction, the co-occurrence of optic and/or peripheral neuropathy with seizures warrants genetic testing for MFF mutations PMID: 26783368
- membrane-anchored Mff differentially regulates various Drp1 isoforms. PMID: 26578513
- Data show that expression of MFF protein, miR-593-5p and BRCA1 protein correlates with cisplatin sensitivity and survival of tongue squamous cell carcinoma (TSCC). PMID: 25912308
- loss of Mff results in failure of Parkin translocation and final clearance of damaged mitochondria PMID: 26008206
- Mitochondrial fission factor (MFF) mRNA is a direct target of miR-27, whose ectopic expression decreases MFF expression through binding to its 3'-untranslated region. PMID: 25431021
- TRAP1 controls mitochondrial fusion/fission balance through Drp1 and Mff expression. PMID: 23284813
- PEX11 proteins attract both Mff and human Fis1 (hFis1) to their site of action. PMID: 22595523
- MFF over-expression results in extensive mitochondrial fragmentation, driving mitochondrial dysfunction. MFF fibroblasts undergo oxidative stress, with increased ROS production, and the onset of autophagy and mitophagy. PMID: 22878233
- MFF gene expression is decreased in both classic and follicular variants of papillary thyroid carcinoma. PMID: 21509594
- Mff is a novel component of a conserved membrane fission pathway used for constitutive and induced fission of mitochondria and peroxisomes. PMID: 18353969
顯示更多
收起更多
-
相關疾病:Encephalopathy due to defective mitochondrial and peroxisomal fission 2 (EMPF2)
-
亞細胞定位:Mitochondrion outer membrane; Single-pass type IV membrane protein. Peroxisome. Cytoplasmic vesicle, secretory vesicle, synaptic vesicle.
-
蛋白家族:Tango11 family
-
組織特異性:Highly expressed in heart, kidney, liver, brain, muscle, and stomach.
-
數據庫鏈接:
Most popular with customers
-
-
YWHAB Recombinant Monoclonal Antibody
Applications: ELISA, WB, IHC, IF, FC
Species Reactivity: Human, Mouse, Rat
-
Phospho-YAP1 (S127) Recombinant Monoclonal Antibody
Applications: ELISA, WB, IHC
Species Reactivity: Human
-
-
-
-
-